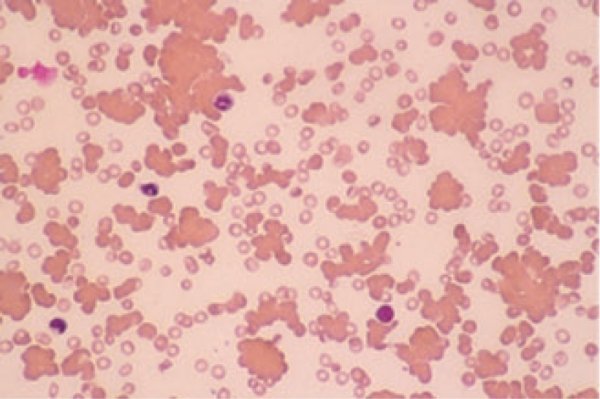
الجودة والتطوير tweet media

Sabitlenmiş Tweet

🎯 تبي تدخل اختبار SLLE وأنت واثق من نفسك؟
ابدأ تحضيرك بطريقة ذكية تعتمد على الفهم العميق — مو الحفظ المؤقت.
🚀 برنامج تدريبي متكامل ومكثّف
مصمّم ليبني أساسك، يقوّي مهاراتك، ويجهّزك للاختبار بثقة.
📘 ماذا ستحصل عليه؟
• سلايدات وملخصات مركّزة تختصر عليك الوقت والجهد
• تبسيط للأفكار المعقّدة بأسلوب واضح ومنظّم
• محتوى يساعدك تراجع بسرعة قبل الاختبار
🧠 +3500 سؤال تجميعي
• مصنّفة حسب المواضيع
• تركيز على الأسئلة المتكررة والنقاط الأكثر أهمية
• مراجعة مركّزة ترفع جاهزيتك للاختبار
🔍 شرح مبسّط خطوة بخطوة
من الأساسيات إلى المهارات المتقدمة
بطريقة تخليك تفهم – تثبّت – وتطبّق بثقة
📅 بداية البرنامج: 1 ابريل 2026
📲 للتسجيل والاستفسار:
wa.me/966533858571


العربية